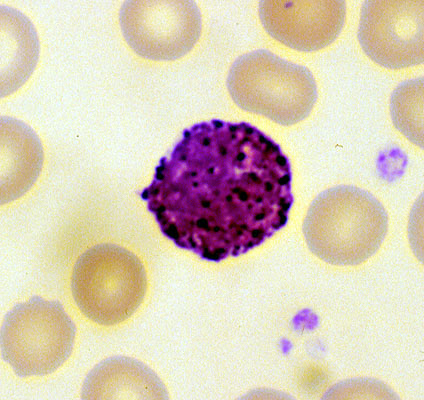

Normal basophil, peripheral blood smear
Click picture to enlarge. Close window to return
Basophils have abundant dark blue granules, which often obscure their segmented nucleus. Basophils compromise 1% of blood leukocytes and are increased in myeloproliferative disorders.